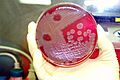

Agente biológico para niños
Un agente biológico es un organismo muy pequeño, como una bacteria, un virus, un parásito o un hongo, o una sustancia dañina que producen estos organismos, llamada toxina. Estos agentes tienen la capacidad de afectar la salud de las personas de diversas maneras.
Los agentes biológicos pueden causar desde reacciones alérgicas leves hasta enfermedades graves. La mayoría de estos organismos se encuentran de forma natural en el medio ambiente, como en el agua, la vegetación, la tierra y los animales. Debido a que pueden reproducirse rápidamente y necesitan pocos recursos para sobrevivir, representan un riesgo potencial en muchas actividades y trabajos.
La Convención sobre Armas Biológicas (BWC, por sus siglas en inglés) es un acuerdo internacional muy importante. Este tratado prohíbe el uso, la distribución o el almacenamiento de agentes biológicos o toxinas que puedan ser usados como armas. Fue firmado en abril de 1972 y entró en vigor en marzo de 1975. Actualmente, 176 países participan en este acuerdo, que busca proteger a la población mundial.
Contenido
¿Cómo se clasifican los agentes biológicos?
Los agentes biológicos se han clasificado de diferentes maneras para entender mejor sus efectos.
Clasificación por sus efectos en la salud
En el pasado, algunos programas de investigación clasificaron los agentes biológicos según el daño que podían causar. Se dividían en:
- Agentes que pueden ser muy peligrosos: Como la bacteria que causa el carbunco (Bacillus anthracis) o la toxina botulínica.
- Agentes que pueden causar enfermedades graves pero no siempre mortales: Como la bacteria Brucella suis o el virus de la encefalitis equina venezolana.
¿Quién regula los agentes biológicos?
Muchos países tienen leyes para controlar los agentes biológicos y proteger la salud pública.
Regulación en Estados Unidos
En Estados Unidos, por ejemplo, se creó una ley en 1997 que identifica los agentes biológicos que podrían representar una amenaza seria para la salud y la seguridad de la población. El Departamento de Salud y Servicios Humanos y el Departamento de Agricultura de ese país son los encargados de supervisar la distribución, posesión y producción de estos agentes.
Los Centros para el Control y Prevención de Enfermedades (CDC) de Estados Unidos clasifican los agentes biológicos conocidos en tres categorías principales: Categoría A, Categoría B y Categoría C.
- Categoría A: Son los agentes más peligrosos. Se transmiten fácilmente entre personas, causan enfermedades graves y requieren una respuesta rápida de las autoridades de salud pública si hay un brote.
- Categoría B: Son agentes que se transmiten con menos facilidad y causan enfermedades con una tasa de mortalidad más baja.
- Categoría C: Incluyen agentes que podrían ser diseñados en el futuro para causar enfermedades a gran escala.
Lista de agentes biológicos y toxinas importantes
A continuación se muestran algunos ejemplos de agentes biológicos y toxinas que han sido estudiados por su importancia. La simbología militar que aparece en las tablas se refiere a códigos usados por el Ejército de Estados Unidos para identificar estos agentes.
Agentes biológicos bacterianos
| Enfermedad | Agente causante (símbolo militar) |
|---|---|
| Carbunco | Bacillus anthracis (N o TR) |
| Brucelosis bovina | Brucella abortus |
| Brucelosis caprina | Brucella melitensis (AM o BX) |
| Brucelosis porcina | Brucella suis (US, AB o NX) |
| Cólera | Vibrio cholerae (HO) |
| Difteria | Corynebacterium diphtheriae (DK) |
| Disentería (bacteriana) | Shigella dysenteriae, algunas especies de Escherichia coli (Y) |
| Muermo | Burkholderia mallei (LA) |
| Listeriosis | Listeria monocytogenes (TQ) |
| Melioidosis | Burkholderia pseudomallei (HI) |
| Peste bubónica | Yersinia pestis (LE) |
| Tularemia | Francisella tularensis (SR o JT) |
Agentes biológicos clamidiales
| Enfermedad | Agente causante (símbolo militar) |
|---|---|
| Psitacosis/sitacosis | Chlamydophila psittaci (SI) |
Agentes biológicos rickettsiales
| Enfermedad | Agente causante (símbolo militar) |
|---|---|
| Fiebre Q | Coxiella burnetii (OU) |
| Fiebre de las Montañas Rocosas | Rickettsia rickettsii (RI o UY) |
| Tifus | Rickettsia prowazekii (YE) |
| Tifus murino | Rickettsia typhi (AV) |
Agentes biológicos virales
| Enfermedad | Agente causante (símbolo militar) |
|---|---|
| Encefalitis equina oriental | Togavirus (ZX) |
| Encefalitis equina venezolana | virus de la encefalitis equina venezolana, un arbovirus del género Alphavirus, familia Togaviridae (FX) |
| Encefalitis equina occidental | virus de la encefalitis equina occidental o virus de la encefalomielitis equina occidental (género Alphavirus, familia Togaviridae= (EV) |
| Encefalitis japonesa B | virus de la encefalitis japonesa (género Flavivirus) (AN) |
| Fiebre del valle del Rift | virus de la fiebre del valle del Rift (FA) |
| Viruela | Variola virus (ZL) |
| Fiebre amarilla | virus de la fiebre amarilla (OJ o LU) |
Agentes biológicos micóticos
| Enfermedad | Agente causante (símbolo militar) |
|---|---|
| Coccidioidomicosis | Coccidioides immitis (OC) |
Toxinas biológicas
| Toxina | Fuente de la toxina (símbolo militar) |
|---|---|
| Toxinas botulínicas (A hasta G) | Clostridium botulinum bacteria o esporas, y otras especies Clostridiales. (X o XR) |
| Ricina | Ricino (Ricinus communis) (W o WA) |
| Saxitoxina | Producida por cianobacterias marinas y de agua dulce, como Anabaena, Aphanizomenon, Lyngbya y Cylindrospermopsis (TZ). |
| Enterotoxina B | Staphylococcus aureus (estafilococo dorado) (UC o PG) |
| Tetrodotoxina | De origen marino, incluye Vibrio alginolyticus y Pseudoalteromonas tetraodonis (PP) |
| Tricoteceno y otras micotoxinas | Varias especies del reino fungi. Incluye Trichoderma y Fusarium. |
Vectores biológicos
| Vector (símbolo militar) | Enfermedad transmitida |
|---|---|
| Mosquito (Aedes aegypti) (AP) | Malaria o paludismo, dengue, chikunguña, fiebre amarilla y arbovirus. |
| Pulga de la rata oriental (Xenopsylla cheopis) | Peste, tifus murino. |
Galería de imágenes
Véase también
- Agente biológico patógeno
- Desecho orgánico
- Especie introducida
- Guerra biológica
- Agroterrorismo
- Niveles de bioseguridad
- Riesgo biológico
- Toxina